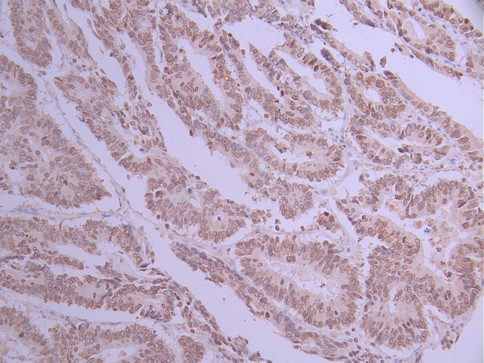

LBR Recombinant Monoclonal Antibody
-
中文名稱:LBR Recombinant Monoclonal Antibody
-
貨號:CSB-RA916460A0HU
-
規格:¥1320
-
圖片:
-
Western Blot
Positive WB detected in: Hela whole cell lysate(30μg), COLO-205 whole cell lysate(30μg), Jurkat whole cell lysate(30μg), K562 whole cell lysate(30μg)
All lanes: LaminB Receptor antibody at 1:1000
Secondary
Goat polyclonal to rabbit IgG at 1/40000 dilution
Predicted band size: 71 kDa
Observed band size: 58 kDa
Exposure time:3min -
IHC image of CSB-RA916460A0HU diluted at 1:100 and staining in paraffin-embedded human colorectal cancer performed on a Leica BondTM system. After dewaxing and hydration, antigen retrieval was mediated by high pressure in a citrate buffer (pH 6.0). Section was blocked with 10% normal goat serum 30min at RT. Then primary antibody (1% BSA) was incubated at 4°C overnight. The primary is detected by a Goat anti-rabbit polymer IgG labeled by HRP and visualized using 0.05% DAB.
-
Overlay Peak curve showing jurkat cells stained with CSB-RA916460A0HU (red line) at 1:100. The cells were fixed in 4% formaldehyde and permeated by 0.2% TritonX-100 for 10min. Then 10% normal goat serum to block non-specific protein-protein interactions followed by the antibody (1ug/1*106cells) for 45min at 4℃. The secondary antibody used was FITC-conjugated goat anti-rabbit IgG (H+L) at 1/200 dilution for 35min at 4℃.Control antibody (green line) was Rabbit IgG (1ug/1*106cells) used under the same conditions. Acquisition of >10,000 events was performed.
-
-
其他:
產品詳情
-
Uniprot No.:
-
基因名:
-
別名:Lamin-B receptor (Integral nuclear envelope inner membrane protein) (LMN2R), LBR
-
反應種屬:Human
-
免疫原:Recombinant Antibody
-
免疫原種屬:Homo sapiens (Human)
-
標記方式:Non-conjugated
-
克隆類型:Monoclonal
-
抗體亞型:Rabbit IgG
-
純化方式:Affinity-chromatography
-
克隆號:18D8
-
濃度:It differs from different batches. Please contact us to confirm it.
-
保存緩沖液:Preservative: 0.03% Proclin 300
Constituents: 50% Glycerol, 0.01M PBS, PH 7.4 -
產品提供形式:Liquid
-
應用范圍:ELISA, WB, IHC, FC
-
推薦稀釋比:
Application Recommended Dilution WB 1:500-1:5000 IHC 1:50-1:200 FC 1:50-1:200 -
Protocols:
-
儲存條件:Upon receipt, store at -20°C or -80°C. Avoid repeated freeze.
-
貨期:Basically, we can dispatch the products out in 1-3 working days after receiving your orders. Delivery time maybe differs from different purchasing way or location, please kindly consult your local distributors for specific delivery time.
-
用途:For Research Use Only. Not for use in diagnostic or therapeutic procedures.
相關產品
靶點詳情
-
功能:Catalyzes the reduction of the C14-unsaturated bond of lanosterol, as part of the metabolic pathway leading to cholesterol biosynthesis. Plays a critical role in myeloid cell cholesterol biosynthesis which is essential to both myeloid cell growth and functional maturation. Mediates the activation of NADPH oxidases, perhaps by maintaining critical levels of cholesterol required for membrane lipid raft formation during neutrophil differentiation. Anchors the lamina and the heterochromatin to the inner nuclear membrane.
-
基因功能參考文獻:
- The authors demonstrate that human LBR is essential for cholesterol synthesis. PMID: 27336722
- These observations point to a new mechanism regulating the localization of LBR, which is governed by an ELYS-mediated phosphorylation network. PMID: 27802161
- The primary response of cells to various stresses leading to senescence consists of the down-regulation of LBR and LB1 to attain reversal of the chromatin architecture. PMID: 27760841
- We have shown here that lamin B receptor (LBR) showed a change in localization in both BrdU-induced and replicative senescent cells. PMID: 27059139
- Data indicate that proto-oncogene protein c-akt (Akt) phosphorylates distinct sites than SRPK1 protein within the arginine-serine (RS) domain of Lamin B Receptor (LBR). PMID: 27105349
- Lamin B receptor mRNA expression was directly associated with tumor grade in breast cancer patients(grade 1 vs. grade 3 - 0.00 vs. 0.00; p = 0.0479) and Nottingham Prognostic Index (NPI1 vs. NPI3 - 0.00 vs. 0.00; p = 0.0551). PMID: 24293108
- Mutation in LBR gene is associated with pelger-huet anomaly and a mild skeletal phenotype. PMID: 23824842
- Lymphohematopoietic licence: sterol C-14 reductase activity of lamin B receptor (Lbr) is essential for neutrophil differentiation. PMID: 22581323
- LBR missense mutations can abolish sterol reductase activity, causing lethal Greenberg dysplasia but not Pelger anomaly PMID: 21327084
- The LBR knockdown cells retain an ovoid shaped nucleus with reduced levels of lamin A/C during in vitro granulopoiesis induced with retinoic acid. PMID: 21327094
- Our studies reveal for the first time a mechanism that controls the timing of nuclear envelope reassembly through modification of the integral nuclear membrane protein lamin B receptor PMID: 21795390
- a highly significant gene-dosage effect between the gene copy number and the nuclear segmentation index of neutrophils PMID: 21326950
- LBR is heavily expressed in papillary thyroid carcinoma cells, but an abnormal folding of the protein might explain its lack of immunohistochemical reactivity and be associated with the anomalous folding of the nuclear membrane. PMID: 21103616
- LBR targets the membrane precursor vesicles to chromatin by interacting with importin beta in a LBR phosphorylation-dependent manner during the NE assembly at the end of mitosis PMID: 20576617
- LBR mutant variants and sterol reductases can severely interfere with the regular organization of the nuclear envelope and the endoplasmic reticulum. PMID: 19940018
- results suggest that LMNA, ZMPSTE24, and LBR sequence variations are not major genetic determinants involved in scleroderma pathogenesis PMID: 19645629
- The binding of lamin B receptor to chromatin is regulated by phosphorylation in the arginine-serine repeat-containing REGION PMID: 11846796
- Mutations in the gene encoding the lamin B receptor produce an altered nuclear morphology in granulocytes (Pelger-Huet anomaly). PMID: 12118250
- Autosomal recessive HEM/Greenberg skeletal dysplasia is caused by 3 beta-hydroxysterol delta 14-reductase deficiency due to mutations in this gene. PMID: 12618959
- examination of temporal association with protamine 1 during spermiogenesis PMID: 14701833
- SR protein kinase and cdc2 kinase regulate lamin B receptor binding to chromatin PMID: 14718546
- MeCP2 interacts in vitro and in vivo with the inner nuclear membrane protein LBR, and the unstructured aminoacidic sequence linking the MBD and TRD domains of MeCP2 is responsible for this association. PMID: 19331822
顯示更多
收起更多
-
相關疾病:Pelger-Huet anomaly (PHA); Greenberg dysplasia (GRBGD); Reynolds syndrome (REYNS)
-
亞細胞定位:Nucleus inner membrane; Multi-pass membrane protein. Endoplasmic reticulum membrane. Cytoplasm. Nucleus.
-
蛋白家族:ERG4/ERG24 family
-
組織特異性:Expressed in the bone marrow, liver, heart, adrenal gland, lung, placenta and uterus. Expressed in osteoclasts and osteoblast-like cells.
-
數據庫鏈接:
Most popular with customers
-
-
YWHAB Recombinant Monoclonal Antibody
Applications: ELISA, WB, IHC, IF, FC
Species Reactivity: Human, Mouse, Rat
-
Phospho-YAP1 (S127) Recombinant Monoclonal Antibody
Applications: ELISA, WB, IHC
Species Reactivity: Human
-
-
-
-
-